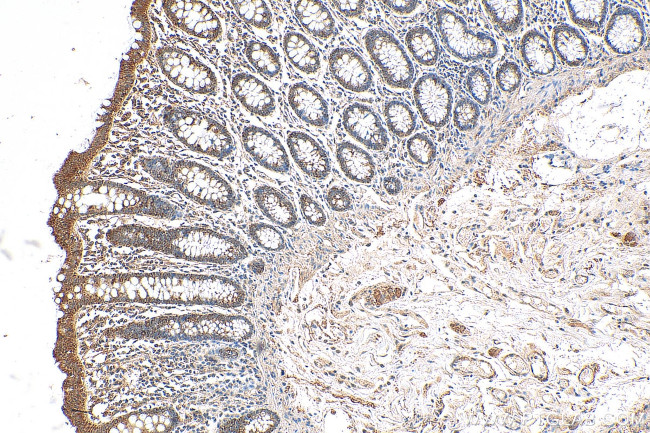
SHPRH Antibody in Immunohistochemistry (Paraffin) (IHC (P))
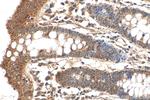
SHPRH Antibody in Immunohistochemistry (Paraffin) (IHC (P))

Search
Proteintech
SHPRH Polyclonal Antibody
{{$productOrderCtrl.translations['antibody.pdp.commerceCard.promotion.promotions']}}
{{$productOrderCtrl.translations['antibody.pdp.commerceCard.promotion.viewpromo']}}
{{$productOrderCtrl.translations['antibody.pdp.commerceCard.promotion.promocode']}}: {{promo.promoCode}} {{promo.promoTitle}} {{promo.promoDescription}}. {{$productOrderCtrl.translations['antibody.pdp.commerceCard.promotion.learnmore']}}
产品信息
21955-1-AP
种属反应
宿主/亚型
分类
类型
抗原
偶联物
形式
浓度
规格
纯化类型
保存液
内含物
保存条件
运输条件
产品详细信息
Immunogen sequence: EYKLLHEYW MALRNRVSAV DELAMATERL RVRDPREPKP NPPVLHIIEP HEVEQNRIKL LNDKAFATSQ LQKKLGQLLY LTNLEKSQDK TSGGVNPEPC PICARQLGKQ WAVLTCGHCF CNECISIIIE QYSVGSHRSS IKCAICRQTT SHKEISYVFT SEKANQEEDI PVKGSHSTKV EAVVRTLMKI QLRDPGAKAL VFSTWQDVLD IISKALTDNN MEFAQISRVK TFQENLSAFK RDPQINILLL PLHTGSNGLT IIEATHVLLV EPILNPAHEL QAIGRVHRIG QTKPTIVHRF LIKATIEERM QAMLKTAERS HTNSSAKHSE ASVLTVADLA DLFTKETEEL E (1334-1683 aa encoded by BC117686)
靶标信息
A novel gene containing SNF2, PHD-finger, RING-finger, helicase, and linker histone domains termed SHPRH, is a possible candidate for a tumor suppressor gene. These domains are characteristic of several DNA repair proteins, transcription factors, and helicases. Mapping of this gene to 6q24, a region reported to contain a tumor suppressor locus suggests a role in tumor suppression.
仅用于科研。不用于诊断过程。未经明确授权不得转售。
篇参考文献 (0)
生物信息学
蛋白别名: 2610103K11Rik; E3 ubiquitin-protein ligase SHPRH; RING-type E3 ubiquitin transferase SHPRH; SNF2 histone linker PHD RING helicase, E3 ubiquitin protein ligase; SNF2, histone-linker, PHD and RING finger domain-containing helicase; unnamed protein product
基因别名: 2610103K11Rik; AA450458; AU024614; bA545I5.2; BC006883; D230017O13Rik; E130018M05; KIAA2023; RAD5; SHPRH
UniProt ID: (Human) Q149N8, (Mouse) Q7TPQ3
Entrez Gene ID: (Human) 257218, (Mouse) 268281